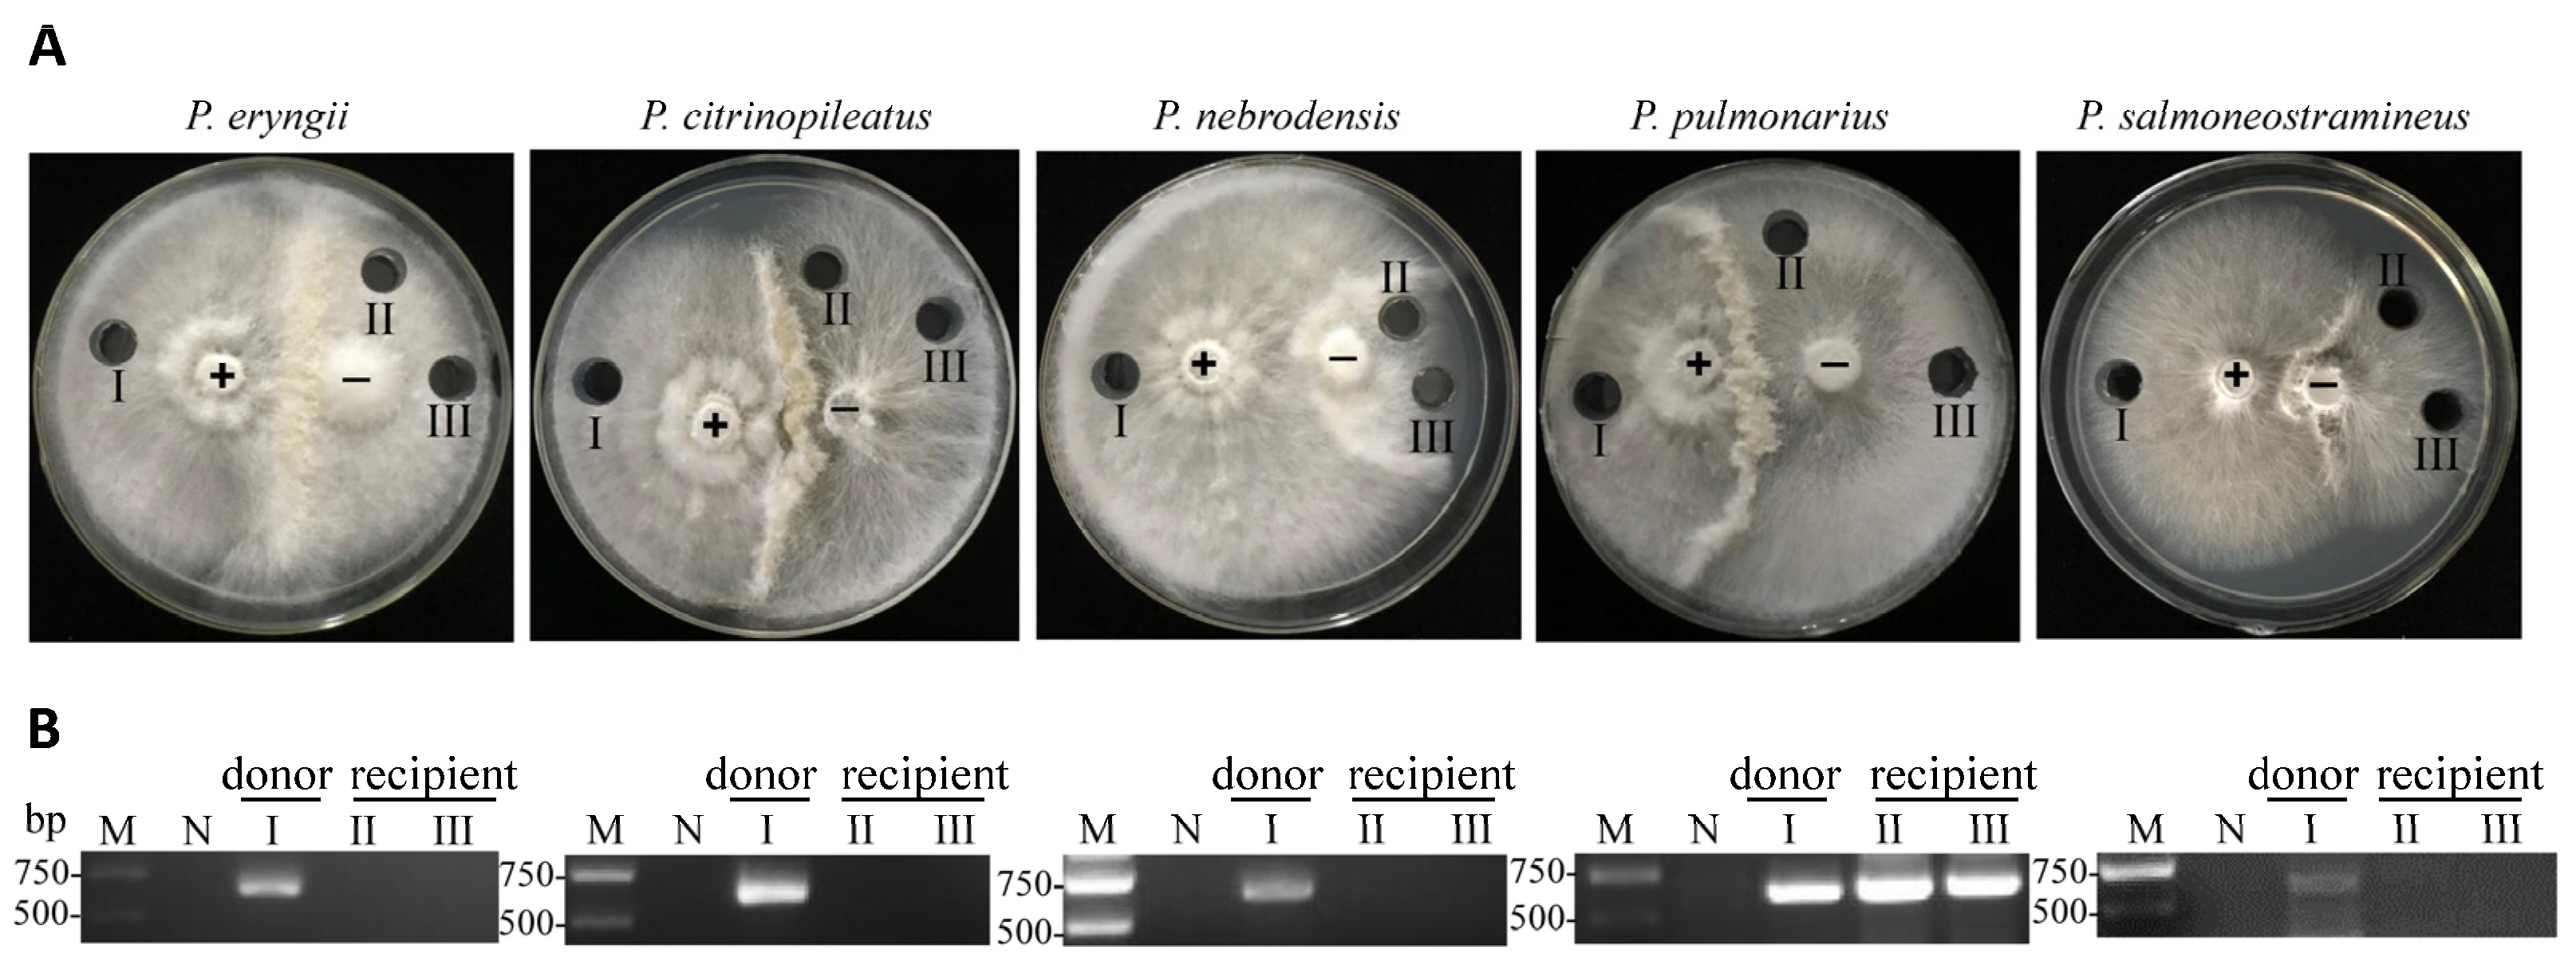
Ijms 24 10584 g001 Ijms 24 10584 g001

Oyster Mushroom Spherical Virus Crosses the Species Barrier and Is Pathogenic to a New Host Pleurotus pulmonarius
Abstract
1. Introduction
2. Results
2.1. OMSV Infects the New Host Pleurotus pulmonarius across the Species Barrier
2.2. OMSV Infection Slows the Mycelial Growth Rate of P. pulmonarius
2.3. Effects of OMSV Infection on the Phenotype of the Fruiting Bodies in P. pulmonarius
2.4. OMSV Infection Reduced Fruiting Body Yield in P. pulmonarius
2.5. Carboxymethyl Cellulase and Laccase Activity in P. pulmonarius Mycelia
3. Discussion
4. Materials and Methods
4.1. Horizontal Transmission of OMSV
4.2. RNA Extraction and Reverse Transcription PCR
4.3. Prokaryotic Expression and Preparation of Polyclonal Antiserum
4.4. Protein Extraction and Western Blot
4.5. Mycelial Growth Rate Measurement
4.6. Cultivation of P. pulmonarius
4.7. Measurement of Enzyme Activity
Supplementary Materials
Author Contributions
Funding
Institutional Review Board Statement
Informed Consent Statement
Data Availability Statement
Acknowledgments
Conflicts of Interest
References
- Hollings, M. Viruses Associated with A Die-Back Disease of Cultivated Mushroom. Nature 1962, 196, 962–965. [Google Scholar] [CrossRef]
- Nibert, M.L.; Ghabrial, S.A.; Maiss, E.; Lesker, T.; Vainio, E.; Jiang, D.; Suzuki, N. Taxonomic reorganization of family Partitiviridae and other recent progress in partitivirus research. Virus Res. 2014, 188, 128–141. [Google Scholar] [CrossRef] [PubMed]
- Myers, J.M.; James, T.Y. Mycoviruses. Curr. Biol. 2022, 32, R150–R155. [Google Scholar] [CrossRef]
- Varga, J.; Vágvölgyi, C.; Tóth, B. Recent advances in mycovirus research. Acta Microbiol. Immunol. Hung. 2003, 50, 77–94. [Google Scholar] [CrossRef]
- Yu, H.J.; Lim, D.; Lee, H.-S. Characterization of a novel single-stranded RNA mycovirus in pleurotus ostreatus. Virology 2003, 314, 9–15. [Google Scholar] [CrossRef] [PubMed]
- Guo, M.; Shen, G.; Wang, J.; Liu, M.; Bian, Y.; Xu, Z. Mycoviral diversity and characteristics of a negative-stranded RNA virus LeNSRV1 in the edible mushroom Lentinula edodes. Virology 2021, 555, 89–101. [Google Scholar] [CrossRef]
- Magae, Y.; Sunagawa, M. Characterization of a mycovirus associated with the brown discoloration of edible mushroom, Flammulina velutipes. Virol. J. 2010, 7, 342. [Google Scholar] [CrossRef] [PubMed]
- Ro, H.-S.; Kang, E.-J.; Yu, J.-S.; Lee, T.-S.; Lee, C.-W.; Lee, H.-S. Isolation and characterization of a novel mycovirus, PeSV, in Pleurotus eryngii and the development of a diagnostic system for it. Biotechnol. Lett. 2006, 29, 129–135. [Google Scholar] [CrossRef]
- Barroso, G.; Labarère, J. Evidence for viral and naked double-stranded RNAs in the basidiomycete Agrocybe aegerita. Curr. Genet. 1990, 18, 231–237. [Google Scholar] [CrossRef]
- Chen, K.; Liang, P.; Yu, M.; Chang, S.T. A new double-stranded RNA virus from Volvariella volvacea. Mycologia 1988, 80, 849–853. [Google Scholar] [CrossRef]
- Huttinga, H.; Wichers, H.J.; Zaayen, A.D.-V. Filamentous and polyhedral virus-like particles in Boletus edulis. Eur. J. Plant Pathol. 1975, 81, 102–106. [Google Scholar] [CrossRef]
- Linnakoski, R.; Sutela, S.; Coetzee, M.P.A.; Duong, T.A.; Pavlov, I.N.; Litovka, Y.A.; Hantula, J.; Wingfield, B.D.; Vainio, E.J. Armillaria root rot fungi host single-stranded RNA viruses. Sci. Rep. 2021, 11, 7336. [Google Scholar] [CrossRef] [PubMed]
- Komatsu, A.; Kondo, H.; Sato, M.; Kurahashi, A.; Nishibori, K.; Suzuki, N.; Fujimori, F. Isolation and characterization of a novel mycovirus infecting an edible mushroom, Grifola frondosa. Mycoscience 2019, 60, 211–220. [Google Scholar] [CrossRef]
- Li, X.; Sui, K.; Xie, J.; Hai, D.; Yin, W.; Sossah, F.L.; Jiang, D.; Song, B.; Li, Y. Molecular characterization of a novel fusarivirus infecting the edible fungus Auricularia heimuer. Arch. Virol. 2020, 165, 2689–2693. [Google Scholar] [CrossRef]
- Sahin, E.; Keskin, E.; Akata, I. Molecular characterization of the complete genome of a novel partitivirus hosted by the saprobic mushroom Leucocybe candicans. Arch. Microbiol. 2021, 203, 5825–5830. [Google Scholar] [CrossRef]
- Sahin, E.; Keskin, E.; Akata, I. Novel and diverse mycoviruses co-inhabiting the hypogeous ectomycorrhizal fungus Picoa juniperi. Virology 2021, 552, 10–19. [Google Scholar] [CrossRef]
- Vainio, E.J.; Sutela, S. Mixed infection by a partitivirus and a negative-sense RNA virus related to mymonaviruses in the polypore fungus Bondarzewia berkeleyi. Virus Res. 2020, 286, 198079. [Google Scholar] [CrossRef]
- Zhu, Q.; Shi, N.; Wang, P.; Zhang, Y.; Peng, F.; Yang, G.; Huang, B. A Novel Gammapartitivirus That Causes Changes in Fungal Development and Multi-Stress Tolerance to Important Medicinal Fungus Cordyceps chanhua. J. Fungi 2022, 8, 1309. [Google Scholar] [CrossRef]
- Li, X.; Li, S.; Yin, W.; Sossah, F.L.; Song, B.; Li, Y.; Zhang, B. Complete genome sequence of a novel mycovirus from Pleurotus citrinopileatus. Arch. Virol. 2023, 168, 66. [Google Scholar] [CrossRef]
- Bellettini, M.B.; Bellettini, S.; Fiorda, F.A.; Pedro, A.C.; Bach, F.; Morón, M.F.F.; Hoffmann-Ribani, R. Diseases and pests noxious to Pleurotus spp. mushroom crops. Rev. Argent Microbiol. 2018, 50, 216–226. [Google Scholar] [CrossRef]
- Zhang, Y.; Gao, J.; Li, Y. Diversity of mycoviruses in edible fungi. Virus Genes 2022, 58, 377–391. [Google Scholar] [CrossRef] [PubMed]
- Xie, J.; Jiang, D. New Insights into Mycoviruses and Exploration for the Biological Control of Crop Fungal Diseases. Annu. Rev. Phytopathol. 2014, 52, 45–68. [Google Scholar] [CrossRef] [PubMed]
- Ghabrial, S.A.; Caston, J.R.; Jiang, D.; Nibert, M.L.; Suzuki, N. 50-plus years of fungal viruses. Virology 2015, 479–480, 356–368. [Google Scholar] [CrossRef]
- Romaine, C.P.; Ulhrich, P.; Schlagnhaufer, B. Transmission of La France isometric virus during basidiosporogenesis in Agaricus bisporus. Mycologia 1993, 85, 175–179. [Google Scholar] [CrossRef]
- Wang, J.; Guo, M.; Sun, Y.; Bian, Y.; Zhou, Y.; Xu, Z. Genetic variation and phylogenetic analyses reveal transmission clues of Lentinula edodes partitivirus 1 (LePV1) from the Chinese L. edodes core collection. Virus Res. 2018, 255, 127–132. [Google Scholar] [CrossRef]
- Won, H.-K.; Park, S.-J.; Kim, D.-K.; Shin, M.J.; Kim, N.; Lee, S.-H.; Kwon, Y.-C.; Ko, H.K.; Ro, H.-S.; Lee, H.-S. Isolation and characterization of a mycovirus in Lentinula edodes. J. Microbiol. 2013, 51, 118–122. [Google Scholar] [CrossRef] [PubMed]
- Liu, Y.; Linder-Basso, D.; Hillman, B.I.; Kaneko, S.; Milgroom, M.G. Evidence for interspecies transmission of viruses in natural populations of filamentous fungi in the genus Cryphonectria. Mol. Ecol. 2003, 12, 1619–1628. [Google Scholar] [CrossRef]
- Cornejo, C.; Hisano, S.; Bragança, H.; Suzuki, N.; Rigling, D. A New Double-Stranded RNA Mycovirus in Cryphonectria naterciae Is Able to Cross the Species Barrier and Is Deleterious to a New Host. J. Fungi 2021, 7, 861. [Google Scholar] [CrossRef]
- O’Connor, E.; Doyle, S.; Amini, A.; Grogan, H.; Fitzpatrick, D.A. Transmission of mushroom virus X and the impact of virus infection on the transcriptomes and proteomes of different strains of Agaricus bisporus. Fungal Biol. 2021, 125, 704–717. [Google Scholar] [CrossRef]
- Hu, H.-J.; Wang, J.-R.; Cheng, X.-H.; Liu, Y.; Zhang, X.-Y. Preliminary Studies on the Effects of Oyster Mushroom Spherical Virus China Strain on the Mycelial Growth and Fruiting Body Yield of the Edible Mushroom Pleurotus ostreatus. Biology 2022, 11, 574. [Google Scholar] [CrossRef]
- Lee, Y.-Y.; de Ulzurrun, G.V.-D.; Schwarz, E.M.; Stajich, J.E.; Hsueh, Y.-P. Genome sequence of the oyster mushroom Pleurotus ostreatus strain PC9. G3 Genes|Genomes|Genetics 2020, 11, jkaa008. [Google Scholar] [CrossRef] [PubMed]
- Ro, H.; Lee, N.; Lee, C.; Lee, H. Isolation of a novel mycovirus OMIV in Pleurotus ostreatus and its detection using a triple antibody sandwich-ELISA. J. Virol. Methods 2006, 138, 24–29. [Google Scholar] [CrossRef]
- Qiu, L.; Li, Y.; Liu, Y.; Gao, Y.; Qi, Y.; Shen, J. Particle and naked RNA mycoviruses in industrially cultivated mushroom Pleurotus ostreatus in China. Fungal Biol. 2010, 114, 507–513. [Google Scholar] [CrossRef]
- Lim, W.-S.; Jeong, J.H.; Jeong, R.-D.; Yoo, Y.B.; Yie, S.W.; Kim, K.-H. Complete nucleotide sequence and genome organization of a dsRNA partitivirus infecting Pleurotus ostreatus. Virus Res. 2005, 108, 111–119. [Google Scholar] [CrossRef]
- Song, H.Y.; Choi, H.J.; Jeong, H.; Choi, D.; Kim, D.H.; Kim, J.M. Viral Effects of a dsRNA mycovirus (PoV-ASI2792) on the vegetative growth of the edible mushroom Pleurotus ostreatus. Mycobiology 2016, 44, 283–290. [Google Scholar] [CrossRef] [PubMed]
- Kim, Y.J.; Kim, J.Y.; Yoon, S.M.; Yoo, Y.-B.; Yie, S.W.; Kim, J.H. The identification of a novel Pleurotus ostreatus dsRNA virus and determination of the distribution of viruses in mushroom spores. J. Microbiol. 2008, 46, 95–99. [Google Scholar] [CrossRef] [PubMed]
- Shahi, S.; Chiba, S.; Kondo, H.; Suzuki, N. Cryphonectria nitschkei chrysovirus 1 with unique molecular features and a very narrow host range. Virology 2020, 554, 55–65. [Google Scholar] [CrossRef]
- Das, S.; Hisano, S.; Eusebio-Cope, A.; Kondo, H.; Suzuki, N. A Transfectable Fusagravirus from a Japanese Strain of Cryphonectria carpinicola with Spherical Particles. Viruses 2022, 14, 1722. [Google Scholar] [CrossRef]
- Lin, P.; Yan, Z.-F.; Kook, M.; Li, C.-T.; Yi, T.-H. Genetic and Chemical Diversity of Edible Mushroom Pleurotus Species. BioMed Res. Int. 2022, 2022, 6068185. [Google Scholar] [CrossRef]
- Kamaruzzaman; He, G.; Wu, M.; Zhang, J.; Yang, L.; Chen, W.; Li, G. A Novel Partitivirus in the Hypovirulent Isolate QT5-19 of the Plant Pathogenic Fungus Botrytis cinerea. Viruses 2019, 11, 24. [Google Scholar] [CrossRef]
- Fuke, K.; Takeshita, K.; Aoki, N.; Fukuhara, T.; Egusa, M.; Kodama, M.; Moriyama, H. The presence of double-stranded RNAs in Alternaria alternata Japanese pear pathotype is associated with morphological changes. J. Gen. Plant Pathol. 2011, 77, 248–252. [Google Scholar] [CrossRef]
- Shapira, R.; Choi, G.H.; Nuss, D.L. Virus-like genetic organization and expression strategy for a double-stranded RNA genetic element associated with biological control of chestnut blight. EMBO J. 1991, 10, 731–739. [Google Scholar] [CrossRef] [PubMed]
- Song, H.-Y.; Kim, N.; Kim, D.-H.; Kim, J.-M. The PoV mycovirus affects extracellular enzyme expression and fruiting body yield in the oyster mushroom, Pleurotus ostreatus. Sci. Rep. 2020, 10, 1094. [Google Scholar] [CrossRef]
- García-Pedrajas, M.D.; Cañizares, M.C.; Sarmiento-Villamil, J.L.; Jacquat, A.G.; Dambolena, J.S. Mycoviruses in Biological Control: From Basic Research to Field Implementation. Phytopathology 2019, 109, 1828–1839. [Google Scholar] [CrossRef] [PubMed]
- Zhong, J.; Chen, D.; Zhu, H.J.; Gao, B.D.; Zhou, Q. Hypovirulence of Sclerotium rolfsii Caused by Associated RNA Mycovirus. Front. Microbiol. 2016, 7, 1798. [Google Scholar] [CrossRef] [PubMed]
- Potgieter, C.A.; Castillo, A.; Castro, M.; Cottet, L.; Morales, A. A wild-type Botrytis cinerea strain co-infected by double-stranded RNA mycoviruses presents hypovirulence-associated traits. Virol. J. 2013, 10, 220–229. [Google Scholar] [CrossRef]
- Rigling, D.; Van Alfen, N.K. Extra- and Intracellular Laccases of the Chestnut Blight Fungus, Cryphonectria parasitica. Appl. Environ. Microbiol. 1993, 59, 3634–3639. [Google Scholar] [CrossRef]
- Zhang, X.; Hu, H.; Wang, Y.; Yan, J.; Liu, Y.; Wang, J.; Cheng, X. Multiplex Detection of Pleurotus ostreatus Mycoviruses. Curr. Issues Mol. Biol. 2022, 44, 5778–5787. [Google Scholar] [CrossRef]
- König, J.; Grasser, R.; Pikor, H.; Vogel, K. Determination of xylanase, β-glucanase, and cellulase activity. Anal. Bioanal. Chem. 2002, 374, 80–87. [Google Scholar] [CrossRef]
- Hou, H.; Zhou, J.; Wang, J.; Du, C.; Yan, B. Enhancement of laccase production by Pleurotus ostreatus and its use for the decolorization of anthraquinone dye. Process. Biochem. 2004, 39, 1415–1419. [Google Scholar] [CrossRef]

| Strains | Period from Inoculation to Harvest (day) | 1st Flush Yield (g/bag) | 2nd Flush Yield (g/bag) |
|---|---|---|---|
| OMSV-free | 29.66 ± 1.52 | 173.9 ± 12.33 | 136.62 ± 10.19 |
| OMSV-infected | 32.00 ± 1.00 | 122.76 ± 6.58 ** | 105.42 ± 11.16 * |
Disclaimer/Publisher’s Note: The statements, opinions and data contained in all publications are solely those of the individual author(s) and contributor(s) and not of MDPI and/or the editor(s). MDPI and/or the editor(s) disclaim responsibility for any injury to people or property resulting from any ideas, methods, instructions or products referred to in the content. |
© 2023 by the authors. Licensee MDPI, Basel, Switzerland. This article is an open access article distributed under the terms and conditions of the Creative Commons Attribution (CC BY) license (https://creativecommons.org/licenses/by/4.0/).
Share and Cite
Zhang, X.; Hu, H.; Zhao, Y.; Wang, Y.; Zhang, W.; You, L.; Wang, J.; Liu, Y.; Cheng, X. Oyster Mushroom Spherical Virus Crosses the Species Barrier and Is Pathogenic to a New Host Pleurotus pulmonarius. Int. J. Mol. Sci. 2023, 24, 10584. https://doi.org/10.3390/ijms241310584
Zhang X, Hu H, Zhao Y, Wang Y, Zhang W, You L, Wang J, Liu Y, Cheng X. Oyster Mushroom Spherical Virus Crosses the Species Barrier and Is Pathogenic to a New Host Pleurotus pulmonarius. International Journal of Molecular Sciences. 2023; 24(13):10584. https://doi.org/10.3390/ijms241310584
Chicago/Turabian StyleZhang, Xiaoyan, Haijing Hu, Yanxiang Zhao, Yifan Wang, Wenjing Zhang, Lunhe You, Jianrui Wang, Yu Liu, and Xianhao Cheng. 2023. "Oyster Mushroom Spherical Virus Crosses the Species Barrier and Is Pathogenic to a New Host Pleurotus pulmonarius" International Journal of Molecular Sciences 24, no. 13: 10584. https://doi.org/10.3390/ijms241310584
APA StyleZhang, X., Hu, H., Zhao, Y., Wang, Y., Zhang, W., You, L., Wang, J., Liu, Y., & Cheng, X. (2023). Oyster Mushroom Spherical Virus Crosses the Species Barrier and Is Pathogenic to a New Host Pleurotus pulmonarius. International Journal of Molecular Sciences, 24(13), 10584. https://doi.org/10.3390/ijms241310584

